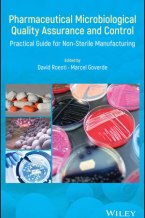

Oil and Security : A World Beyond Petroleum
This book examines the economic impact of changes in the global demand and supply for fossil fuels both on the major producers ...
Lee mas
Pharmaceutical Microbiological Quality Assurance and Control : Practical Guide for Non-Sterile Manufacturing / David Roesti
Offers a comprehensive guidance for non-sterile pharmaceuticals microbiological QA/QC Presents the latest developments in ...
Lee masPharmaceutical Quality by Design: A Practical Approach / Walkiria S. Schlindwein, Mark Gibson
Outlines a new and proven approach to pharmaceutical product development which is now being rolled out across the pharmaceutical ...
Lee mas
Plasma Assisted Decontamination of Biological and Chemical Agents
Plasma decontamination is a rapidly expanding area of modern science and engineering. This book provides a fundamental introduction ...
Lee mas
Polyvinylpyrrolidone Excipients for Pharmaceuticals
The book describes the properties, analytical methods and the applications of different polyvinylpyrrolidone excipients (povidone, ...
Lee mas
Powders and Bulk Solids
The book concentrates on powder flow properties, their measurement and applications. These topics are explained starting ...
Lee mas
Precision Manufacturing
Provides an introduction to precision engineering for manufacturing. This book places emphasis on design and performance ...
Lee mas
Prevention, Detection and Response to Nuclear and Radiological Threats
The primary goal of any counter-terrorism effort is to prevent an attack as early in the development stages as possible. ...
Lee mas
Product Reliability : Specification and Performance
Product Reliability develops a framework which links reliability specifications and product performance in the context of ...
Lee mas
Quality Control & Safety Evaluation of Natural Products / Shuang-Qing Zhang, Hongtao Jin, Feng Wei, Xiaohui Ma
Natural medicines are derived from natural sources such as plants, animals and/or mineral origins. The use of traditional ...
Lee masQuality Planning and Assurance: Principles, Approaches, and Methods for Product and Service Development / Herman Tang
In Quality Planning and Assurance: Principles, Approaches, and Methods for Product and Service Development, accomplished ...
Lee mas
Recent Advances in Reliability and Quality in Design
Recent Advances in Reliability and Quality in Design presents the latest theories and methods of reliability and quality, ...
Lee mas
Regional Climate Studies of China
Regional Climate of China is the first volume to present the latest research findings gained over the last decade which has ...
Lee masReliability Engineering
This book shows how to build in, evaluate, and demonstrate reliability & availability of components, equipment, systems. ...
Lee mas
Reliability in Automotive and Mechanical Engineering : Determination of Component and System Reliability
The volume brings together eleven chapters to highlight the importance of the interrelated reliability and maintenance disciplines. ...
Lee masReliability-based Structural Design
Reliability-based Structural Design provides readers with an understanding of the fundamentals and applications of structural ...
Lee mas
Risks in Modern Society
The main goal of this book is to make the reader familiar with the complexity and multi-dimensionality of the subject RISK, ...
Lee masSafer Healthcare : Strategies for the Real World
The authors of this book set out a system of safety strategies and interventions for managing patient safety on a day-to-day ...
Lee mas
Safety for Particle Accelerators
The use of non-standard technologies such as superconductivity, cryogenics and radiofrequency pose challenges for the safe ...
Lee mas
Sanificazione nellindustria alimentare = Sanitation in the food industry
This volume is the Italian version of the original Principles of Food Sanitation, now in its fifth edition, whose validity ...
Lee mas